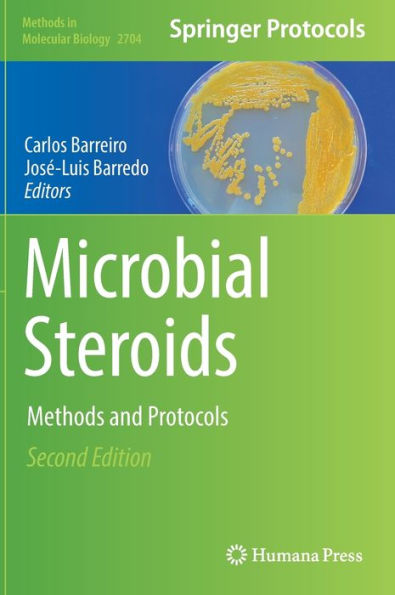
Microbial Steroids: Methods and Protocols

Home
Microbial Biotechnology: Methods and Applications
Barnes and Noble
Loading Inventory...
Microbial Biotechnology: Methods and Applications in Chattanooga, TN
Current price: $148.00

Barnes and Noble
Microbial Biotechnology: Methods and Applications in Chattanooga, TN
Current price: $148.00
Loading Inventory...
Size: OS
Microbes are microscopic organisms, which include bacteria, viruses, fungi, protozoa and microalgae. They inhabit the soil, water, rocks, hot springs, food and animal intestines. Such a wide diversity in microbial habitats points to a diversity of microbial metabolic and biochemical traits which gives rise to such genetic variation and natural selection in populations of microbes. Microbial biotechnology is a sub-field of biotechnology that aims to develop better vaccines and diagnostic tools, microbial agents for the biological control of pests in animals and plants, novel industrial catalysts and fermentation agents as well as agents for the bioremediation of contaminated soil and water. Research in this field can be crucial in the areas of food safety and security, human nutrition, animal and plant protection, etc. This book discusses the fundamentals as well as modern approaches of microbial biotechnology. It unravels the recent studies in this field with respect to novel methods, techniques and applications of microbial biotechnology. It will prove to be immensely beneficial to students and researchers in this field.
Microbes are microscopic organisms, which include bacteria, viruses, fungi, protozoa and microalgae. They inhabit the soil, water, rocks, hot springs, food and animal intestines. Such a wide diversity in microbial habitats points to a diversity of microbial metabolic and biochemical traits which gives rise to such genetic variation and natural selection in populations of microbes. Microbial biotechnology is a sub-field of biotechnology that aims to develop better vaccines and diagnostic tools, microbial agents for the biological control of pests in animals and plants, novel industrial catalysts and fermentation agents as well as agents for the bioremediation of contaminated soil and water. Research in this field can be crucial in the areas of food safety and security, human nutrition, animal and plant protection, etc. This book discusses the fundamentals as well as modern approaches of microbial biotechnology. It unravels the recent studies in this field with respect to novel methods, techniques and applications of microbial biotechnology. It will prove to be immensely beneficial to students and researchers in this field.